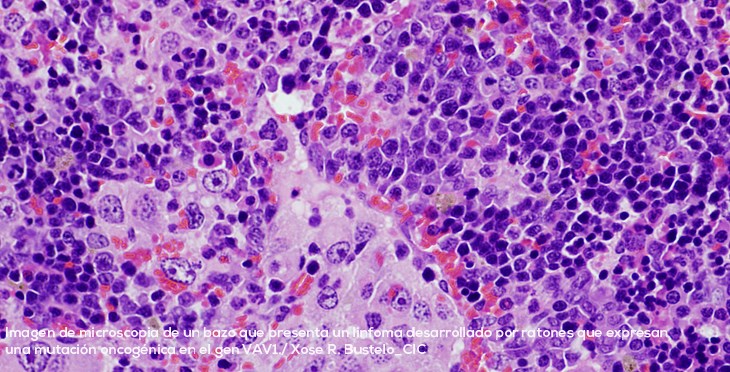
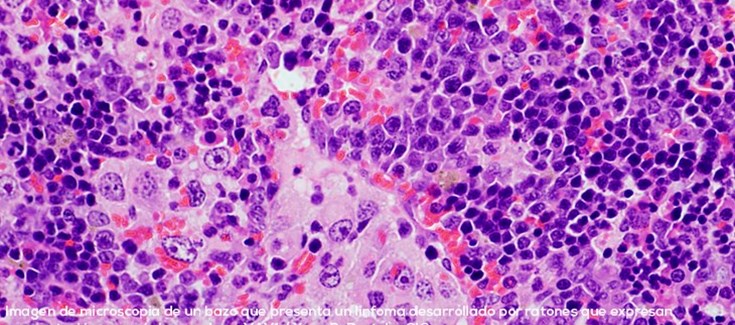

Los estudios recientes de secuenciación del genoma de un amplio número de tumores han revelado que éstos albergan miles de alteraciones genéticas (denominadas mutaciones). Esto ha creado un nuevo problema: saber cuáles son las que son importantes para el desarrollo del cáncer o la adquisición de sus propiedades malignas, si lo son de forma autónoma o necesitan el concurso de otras alteraciones genéticas simultáneamente y, finalmente, si se pueden identificar vulnerabilidades asociadas a estas alteraciones genéticas que permitan desarrollar nuevas terapias anti-tumorales. La resolución de estos problemas no es fácil por dos razones fundamentales: la mayoría de estas alteraciones genéticas tienen efectos neutros en las células tumorales y, debido a ello, son irrelevantes para el desarrollo o la progresión maligna de los tumores que los albergan. Muchas de las alteraciones genéticas que sí tienen un papel relevante en cáncer se encuentran a muy baja frecuencia en los pacientes. Debido a ello, la identificación de las alteraciones genéticas que sí son relevantes es como buscar una aguja minúscula en un gran pajar, y continúa siendo un gran reto científico.
El grupo de investigación liderado por el Dr. Xosé R. Bustelo, perteneciente al Centro de Investigación del Cáncer (CIC) del CSIC y la Universidad de Salamanca así como al Programa de Mecanismos de Progresión Tumoral del Centro de Investigación Biomédica en Red de Cáncer (CIBERONC), acaba de publicar un artículo científico en donde se ha identificado que una alteración genética que afecta al gen conocido por VAV1 tiene papeles importantes en tumores derivados de los linfocitos T (linfomas) y del pulmón. En este estudio, cuyo primer firmante es el investigador del CIC y CIBERONC Dr. Javier Robles-Valero, también ha permitido descubrir que esta alteración genética desempeña funciones pro-tumorales diferentes dependiendo del tipo de órgano en donde surge.
Como indica el Dr. Javier Robles-Valero, primer autor de este trabajo, “el papel de esta alteración genética en el gen VAV1 era muy intrigante, porque se detectaba en tumores derivados de células que, como los linfocitos T responsables de nuestras respuestas inmunes, sí expresaban de forma normal este gen. Sin embargo, también se detectaba en algunos tumores que, como era el caso del cáncer de pulmón, derivaban de células que normalmente no expresaban esta proteína. Esto nos hizo preguntarnos si esta alteración genética era importante en ambos casos y, en dicho caso, intentar conocer los mecanismos que influencian el desarrollo de estos tumores”.
Para abordar estas preguntas, el grupo de investigación del Dr. Bustelo ha generado un modelo de ratón modificado genéticamente que contenía la alteración genética en el gen VAV1 encontrada previamente en pacientes. Posteriormente, este ratón se ha cruzado con otros que poseían otras alteraciones genéticas frecuentemente encontradas en pacientes como las que afectaban al gen antitumoral TP53 y al gen pro-tumorigénico KRAS. El estudio de todas estas cepas de ratones ha indicado que la alteración genética en el gen VAV1 no es suficiente para inducir la formación de tumores en ningún órgano de los ratones. Sin embargo, cuando se combina con la eliminación del gen supresor TRP53, ello provoca el rápido desarrollo de un tumor muy específico de linfocitos T conocido con el nombre de linfoma periférico de células T. Curiosamente, estos tumores tienen características idénticas a los que se encuentran en pacientes. En cambio, no se han detectado otros tipos tumorales, indicando que la combinación de estas dos alteraciones genéticas da lugar a solo un tipo de tumor.
Dado que estos ratones no desarrollan tumores de pulmón, los investigadores decidieron comprobar si ello se debe a que las mutaciones de VAV1 necesitan en ese caso el concurso de alteraciones genéticas en otros genes. Ello es así, porque los ratones que poseen alteraciones genéticas que activaban los genes VAV1 y KRAS sí desarrollan tumores de pulmón. Ello es probablemente debido a que, a diferencia de la eliminación del gen TP53, la activación del gen KRAS conlleva la expresión del gen VAV1 en células de pulmón que, en condiciones normales, nunca expresan este último gen. Como indica el Dr. Bustelo, director del trabajo, “Estos resultados nos han dado una información importante sobre las alteraciones genéticas encontradas en el gen VAV1 en pacientes con cáncer: por un lado, nos ha demostrado que éstas sí tienen un papel relevante en el origen de unos tipos tumorales muy concretos. Por otro lado, también nos indica que para ello la mutación en el gen VAV1 necesita cooperar con otras alteraciones genéticas presentes en otros genes en las células que originan los tumores y que, dependiendo de cuáles sean éstas, VAV1 puede inducir un tipo tumoral u otro. Finalmente, la caracterización de cada uno de estos tumores nos ha permitido identificar dianas terapéuticas potenciales para matar los tumores que poseen las alteraciones genéticas en el gen VAV1”.
Junto con estos resultados que han permitido descubrir un nuevo gen inductor de cáncer así como las debilidades terapéuticas de los tumores positivos para la alteración genética en el gen VAV1, el interés del trabajo viene dado también por los modelos animales que se han desarrollado puesto que, como indica el Dr. Robles-Valero, “éstos servirán de base para seguir estudiando el desarrollo progresivo de estos dos tipos de tumores y, sobre todo, para ser usados para ensayar nuevos fármacos contra los mismos. En este sentido, conviene recordar que estos linfomas y tumores de pulmón se caracterizan, todavía hoy, por tener tasas de supervivencia muy bajas de los pacientes”.
Apoyo al trabajo
Este trabajo representó un “tour de forcé” de varios años donde han colaborado diferentes investigadores españoles a nivel internacional pertenecientes al Centro de Investigación del Cáncer de Salamanca, el CIBER en cáncer, la Universidad de Navarra y el Instituto Gulbenkian de Lisboa.
La realización del trabajo fue posible gracias a financiación recibida desde la Fundación “La Caixa”, la Asociación Española contra el Cáncer (AECC), el Ministerio de Ciencia e Innovación, el Instituto de Salud Carlos III y la Junta de Castilla y León.
Referencia del artículo
Autores: Javier Robles-Valero; Lucía Fernández-Nevado; Myriam Cuadrado; Luis Francisco Lorenzo-Martín; Isabel Fernández-Pisonero; Antonio Abad; Esther Redín; Luis Montuenga; Dionisio Martín-Zanca; Anna Bigas; Moisés Mallo; Mercedes Dosil y Xosé R Bustelo
Acceso a publicación:
https://febs.onlinelibrary.wiley.com/doi/full/10.1002/1878-0261.13295
Acceso al vídeo (inglés):
https://youtu.be/oYPAGGrL_Ck?list=PLfb_Y2oKMFRNVOVM8CIKRvX1h1Yl-1ELB